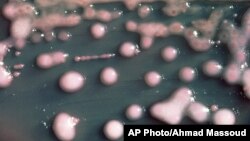
FILE - One form of CRE bacteria, sometimes called “nightmare bacteria.” CRE bacteria, blamed for 600 deaths each year, and can withstand treatment from virtually every type of antibiotic.

GENEVA —
The World Health Organization warns (WHO) resistance to antibiotics is spreading to all regions around the world and is now a major threat to public health. A new WHO report analyzes data from 114 countries. It finds antibiotics are no longer effective in treating potentially life-threatening illnesses in a growing number of people.
This report is the first and most comprehensive look at antimicrobial resistance. It presents a frightening view of a world without effective antibiotics to treat common infections. The World Health Organization says this serious threat is not a prediction for the future. It is happening right now in every region of the world.
The report focuses on antibiotic resistance in seven different bacteria, which are responsible for common, serious diseases, such as diarrhea, pneumonia, urinary tract infections and gonorrhea.
WHO’s Assistant Director-General for Health Security, Keiji Fukuda, says hospitals in all regions of the world are reporting untreatable or nearly untreatable infections.
“If we take a look at an important infection like gonorrhea, this is an infection which affects about one million people per day, an important sexually transmitted disease. We now see that 10 countries have reported finding gonorrhea, which is untreatable by any antibiotics. We have no medical treatment for this infection in many of these instances," said Fukuda.
Among those countries are Austria, Canada, Japan, South Africa, Sweden and the United Kingdom. Untreated gonorrhea can cause infertility, ectopic pregnancy and blindness in babies born to infected mothers.
The WHO report also notes that treatment of some urinary tract infections is now ineffective in more than half of patients. It says antibiotic resistance causes people to be sick for longer periods and increases the risk of death.
Health officials cite the misuse and inappropriate use of drugs and the practice of adding antibiotics to agricultural feed to fatten animals as some of the factors leading to growing antibiotic resistance.
Dr. Fukuda says the health care system relies on these medicines to protect people when they are most vulnerable.
“It means that when people develop cancer and are on chemotherapy and become immuno-compromised, they are at much higher risk for complications and infections and severe ones. When babies are born prematurely, they are in the same situation. When we have children who are malnourished, they are at much higher risk for infection," he said.
He says similar devastating scenarios are playing out whenever people go in for surgery. Dr. Fukuda warns more people are likely to die from these infections. He notes resistance also increases the cost of health care, with lengthier stays in the hospital and more intensive care required.
He says effective antibiotics have been one of the pillars allowing people to live longer, healthier lives. He warns everyone will suffer from antibiotic resistance, especially those in poor, developing countries.
The World Health Organization is using this report to kick-start a global effort to address drug resistance. It says nations and people should view these findings as a wake-up call for a global plan of action to tackle this growing problem. It says efforts must be intensified to educate people and increase awareness of the looming dangers. And it says tools and medications must be developed to replace those that are becoming ineffective.
Related report by Zlatica Hoke:
This report is the first and most comprehensive look at antimicrobial resistance. It presents a frightening view of a world without effective antibiotics to treat common infections. The World Health Organization says this serious threat is not a prediction for the future. It is happening right now in every region of the world.
The report focuses on antibiotic resistance in seven different bacteria, which are responsible for common, serious diseases, such as diarrhea, pneumonia, urinary tract infections and gonorrhea.
WHO’s Assistant Director-General for Health Security, Keiji Fukuda, says hospitals in all regions of the world are reporting untreatable or nearly untreatable infections.
“If we take a look at an important infection like gonorrhea, this is an infection which affects about one million people per day, an important sexually transmitted disease. We now see that 10 countries have reported finding gonorrhea, which is untreatable by any antibiotics. We have no medical treatment for this infection in many of these instances," said Fukuda.
Among those countries are Austria, Canada, Japan, South Africa, Sweden and the United Kingdom. Untreated gonorrhea can cause infertility, ectopic pregnancy and blindness in babies born to infected mothers.
The WHO report also notes that treatment of some urinary tract infections is now ineffective in more than half of patients. It says antibiotic resistance causes people to be sick for longer periods and increases the risk of death.
Health officials cite the misuse and inappropriate use of drugs and the practice of adding antibiotics to agricultural feed to fatten animals as some of the factors leading to growing antibiotic resistance.
Dr. Fukuda says the health care system relies on these medicines to protect people when they are most vulnerable.
“It means that when people develop cancer and are on chemotherapy and become immuno-compromised, they are at much higher risk for complications and infections and severe ones. When babies are born prematurely, they are in the same situation. When we have children who are malnourished, they are at much higher risk for infection," he said.
He says similar devastating scenarios are playing out whenever people go in for surgery. Dr. Fukuda warns more people are likely to die from these infections. He notes resistance also increases the cost of health care, with lengthier stays in the hospital and more intensive care required.
He says effective antibiotics have been one of the pillars allowing people to live longer, healthier lives. He warns everyone will suffer from antibiotic resistance, especially those in poor, developing countries.
The World Health Organization is using this report to kick-start a global effort to address drug resistance. It says nations and people should view these findings as a wake-up call for a global plan of action to tackle this growing problem. It says efforts must be intensified to educate people and increase awareness of the looming dangers. And it says tools and medications must be developed to replace those that are becoming ineffective.
Related report by Zlatica Hoke: